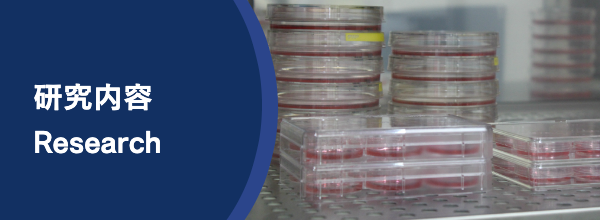

Using human cultured cells as a model system, we aim to understand the mechanisms that maintain genome stability within cells by applying the auxin-inducible degron (AID) technology that we developed. Genome instability can lead to cellular senescence, hereditary diseases, and cancer, so our research is expected to contribute to the fundamental understanding of these phenomena.
New Cell Genetics Enabled by the Auxin-Inducible Degron (AID) System
Using the AID system developed in our laboratory, it has become possible to generate human AID-mutant cell lines (see Auxin-Inducible Degron Method for details). This technology now allows functional analysis of the approximately 9% of human genes thought to be essential for cell proliferation. We are planning a comprehensive AID-based analysis of these essential genes.
Advancing Protein Control Using the Auxin-Inducible Degron (AID) System
To make the AID system more versatile, we are improving the technology by incorporating chemical biology approaches—such as the use of auxin analogs—and advances in genome editing. We are also extending its application to stem cells.
Cells possess multiple mechanisms to maintain stable replication forks
For a cell to proliferate, it must replicate the genome DNA, which stretches nearly 2 meters in length within a single human cell. Replication forks unwind the DNA double helix as they proceed, but they encounter various obstacles during this process. To overcome these problems and ensure accurate DNA replication, cells have developed multiple protective mechanisms.
Using the AID system to degrade replication fork components, we aim to uncover the intrinsic defense mechanisms of replication forks. In particular, we focus on the relationship between DNA replication and homologous recombination repair, and we are working to elucidate the mechanisms by which cells maintain genome stability.
Webinar (Feb 3, 2021)
Intervirew
Public lecture video (Nov 2, 2014)








